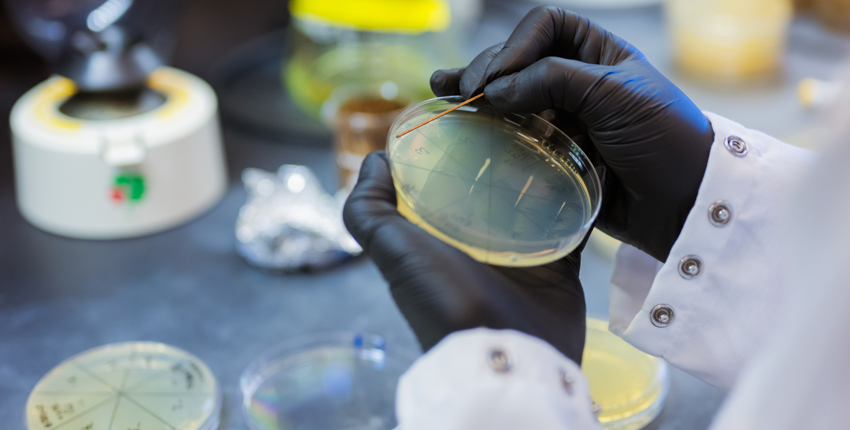
Closeup of petri dish

Therapeutics Initiative
Therapeutics Initiative
Advancing therapeutics research, accelerating the translation of our discoveries toward important medicines, and training the inventors of those future medicines
Advancing therapeutics research, accelerating the translation of our discoveries toward important medicines, and training the inventors of those future medicines
Blavatnik Harvard Life Lab Longwood
Blavatnik Harvard Life Lab Longwood
10,000-square-foot laboratory and co-working space located in the heart of Longwood
10,000-square-foot laboratory and co-working space located in the heart of Longwood
Blavatnik Therapeutics Challenge Awards
Blavatnik Therapeutics Challenge Awards
Accelerating the translation of discoveries made at HMS into new medicines
Accelerating the translation of discoveries made at HMS into new medicines
Quadrangle Fund for Advancing and Seeding Translational Research
Quadrangle Fund for Advancing and Seeding Translational Research
Early-stage research with commercialization potential
Early-stage research with commercialization potential
© 2026 by the President and Fellows of Harvard College